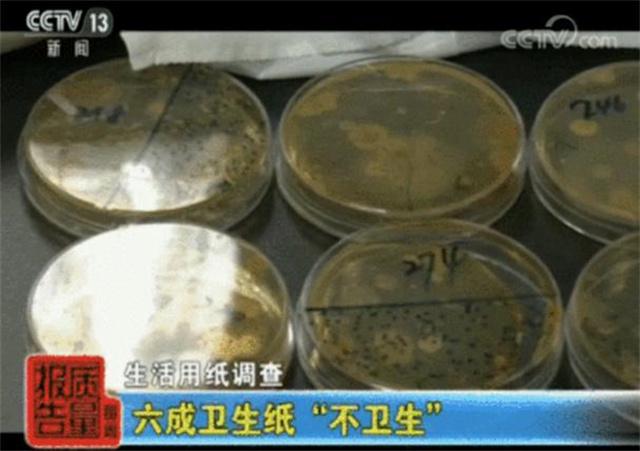
315曝光:已经被国家点名的4个“物件”风险太大最好不买(图5)

,单纯从成分来看,并未有问题,纵然是提到属于“低毒”的表面活性剂也是如此。
经研究显示,每千克的体重要吃进大概8g表面活性剂才会引起中毒,就好比一个体重在60公斤的人要至少喝掉一大桶不稀释的洗洁精才会出现中毒反应。

而中毒的概率便和每天食盐过度的概率差不多,之所以说“会中毒”便是那些甲醛超标、不合格的洗洁精。
而以下几种务必避开,洗洁精香味过于浓烈,香味过浓一般便被看作与化学污染物有关。

另外便是散装洗洁精,虽然价格便宜,但制作过程是否达标谁都无法清楚,其中的菌落总数以及pH值都有可能超标谁都无法预料。
再者便是分层以及浑浊尤为明显的洗洁精,这种是最为肉眼可见务必要避开的洗洁精选项,所以选择洗洁精万不得贪图便宜,还是要认准相关品牌。


“一元秒杀纸巾”“纸巾赔本处理”,听来都并非陌生,但其中这纸巾到底好坏谁都难以清楚,这到底是质量上乘的卫生纸亦或是劣质卫生纸。
按照商人逐利的角度,纵然是上等卫生纸赔本买卖,但概率终是不大,也就成了大众闻起来很臭的“卫生纸”,也是常说的“毒卫生纸”。
而从哪多见这“劣质”?公共厕所的卫生纸巾桶、大排档的卫生纸盒、闻起来香香且带有印花的纸......
听来尤为平常,但是轻则患上皮炎、肠炎、甚至患上呼吸疾病,长期使用还会患上白血病,央视报道曾查获一批不合格卫生纸,发现商家为控制成本,便会在制作过程原料上动手脚。

甚至有其他商家会选择直接用回收的废纸原料、生活垃圾进行再加工,而为显示出卫生纸的“白”会添加大量荧光增白剂或者工业滑石粉。

太便宜的不要买,不清楚作坊也不清楚用料,还是要认清楚正规的大品牌,卫生纸这种贴肤的物件还是不要贪图便宜为好。
其二发现没有产品明细、没有消准字号、注明原材料这些都不买;其三有明显掉絮、松散以及发现纸巾上有明显异味不要买,很可能添加漂白剂等有害物质。


防火玻璃顾名思义便是为防火,但315曝光,这不达标的防火玻璃样品,仅仅在燃烧3到7分钟后便出现爆裂。
且相关玻璃生产负责人表示,检测报告也存在夸大嫌疑,检测报告显示防火一个半小时,但实际玻璃防火只能达到半小时。

防火玻璃近些年俩并非稀奇,便是这高层之上一般在18层以上配备相应的防火玻璃,一般多见于写字楼等建筑。
但却也令人无奈是“假冒的防火玻璃”难禁,根据相关工人所言,便是因为这真的防火玻璃成本太高。

要清楚,一般在大型工程里,防火玻璃大概占据所用玻璃量10%,而防火玻璃的成本要比普通玻璃高出50%,防火玻璃的成本要比普通玻璃高出七八十元。
以50万平方米面积来说,基本需要1000平方米防火玻璃,相比普通玻璃成本便要高出达到近乎10万元。

所以作为消费者,想要购买防火玻璃便选择去到具有生产防火玻璃资格认证的公司去购买,当然对于相关机构,即使是具有资质的玻璃厂家也要做到实打实不定期的抽查与检验。

仿瓷餐具,实际只是一个俗称,市面上仿瓷碗材料基本是由三聚氰胺和甲醛聚合而成的高分子聚合材料,简单来说便是“密胺树脂”。

同时预示着贵,也就是说真正的仿瓷用具实际并不便宜,也便出现了“平替”,以脲醛树脂材质做成的“仿瓷碗”。
看着是好看,但是接触到的水分越多,酸性也更为明显,温度也就越高,水解也会更严重,随即的结果便是甲醛更多。

实际4种“物件”点名的清楚,但却也发现,为何央视已经曝光但如今市场仍屡禁不止。

一来,是造假的人仍旧存在,二来监管的速度追不上造假的速度,一如日前打击的“含绒量为0%”的羽绒服,从吊牌到合格证均有一批完整的产业链且分布甚广。

但对于日常的消费者而言,也要多个心眼,这仿瓷碗含有高甲醛,那在进行买碗之时,便要认清楚含有“MF”和“QS”标志的碗再进行购买。
而市场监管是市场监管,但为避免更大的风险,作为消费者,务必记得什么可以买什么不可以买也是关键。
